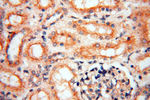
INPP5E Antibody in Immunohistochemistry (Paraffin) (IHC (P))
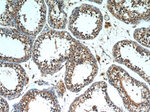
INPP5E Antibody in Immunohistochemistry (Paraffin) (IHC (P))

Search
Proteintech
INPP5E Polyclonal Antibody
{{$productOrderCtrl.translations['antibody.pdp.commerceCard.promotion.promotions']}}
{{$productOrderCtrl.translations['antibody.pdp.commerceCard.promotion.viewpromo']}}
{{$productOrderCtrl.translations['antibody.pdp.commerceCard.promotion.promocode']}}: {{promo.promoCode}} {{promo.promoTitle}} {{promo.promoDescription}}. {{$productOrderCtrl.translations['antibody.pdp.commerceCard.promotion.learnmore']}}
产品信息
17797-1-AP
种属反应
已发表种属
宿主/亚型
分类
类型
抗原
偶联物
形式
浓度
规格
纯化类型
保存液
内含物
保存条件
运输条件
产品详细信息
Immunogen sequence: MPSKAENLR PSEPAPQPPE GRTLQGQLPG APPAQRAGSP PDAPGSESPA LACSTPATPS GEDPPARAAP IAPRPPARPR LERALSLDDK GWRRRRFRGS QEDLEARNGT SPSRGSVQSE GPGAPAHSCS PPCLSTSLQE IPKSRGVLSS ERGSPSSGGN PLSGVASSSP NLPHRDAAVA GSSPRLPSLL PPRPPPALSL DIASDSLRTA NKVDSDLADY KLRAQPLLVR AHSSLGPGRP RSPLACDDCS LRSAKSSFSL LAPIRSKDVR SRSYLEGSLL ASGALLGADE LARYFPDRNV ALFVATWNMQ GQKELPPSLD EFLLPAEADY AQDLYVIGVQ EGCSDRREWE T (1-350 aa encoded by BC028032)
靶标信息
INPP5E (inositol polyphosphate 5-phosphatase), also known as phosphatidylinositol polyphosphate 5-phosphatase type IV, is a 644 amino acid peripheral membrane protein associated with Golgi stacks. Belonging to the inositol-1, 4, 5-trisphosphate 5-phosphatase type IV family, INPP5E converts phosphatidylinositol-3, 4, 5-triphosphate (PtdIns 3, 4, 5-P3) to PtdIns-P2. While inactive towards water soluble inositol phosphates, the activity of INPP5E is specific for lipid substrates. INPP5E becomes phosphorylated upon DNA damage and is expressed in brain, heart, pancreas, testis and spleen. Defects in INPP5E are the cause of Joubert syndrome type 1 (JBTS1), a disorder presenting with cerebellar ataxia, oculomotor apraxia, hypotonia, neonatal breathing abnormalities and psychomotor delay. In addition, mutations in the INPP5E gene may lead to mental retardation-truncal obesity-retinal dystrophy-micropenis (MORMS), an autosomal recessive disorder characterized by moderate mental retardation, truncal obesity, congenital non-progressive retinal dystrophy, and micropenis in males.
仅用于科研。不用于诊断过程。未经明确授权不得转售。
生物信息学
蛋白别名: 5-phosphatase that induces arborization; 72 kDa inositol polyphosphate 5-phosphatase; inositol polyphosphate 5-phosphatase; Inositol polyphosphate-5-phosphatase E; inositol polyphosphate-5-phosphatase, 72 kDa; Pharbin; phosphatidylinositol (4,5) bisphosphate 5-phosphatase homolog; Phosphatidylinositol 4,5-bisphosphate 5-phosphatase; phosphatidylinositol 5-phosphatase; Phosphatidylinositol polyphosphate 5-phosphatase type IV; Phosphatidylinositol-3,4,5-trisphosphate 5-phosphatase; phosphatidylinositol-4,5-bisphosphate 5-phosphatase
基因别名: 1200002L24Rik; 72kDa; CORS1; CPD4; INPP5E; JBTS1; mKIAA0123; MORMS; pharbin; PPI5PIV
UniProt ID: (Human) Q9NRR6, (Rat) Q9WVR1, (Mouse) Q9JII1
Entrez Gene ID: (Human) 56623, (Rat) 114089, (Mouse) 64436